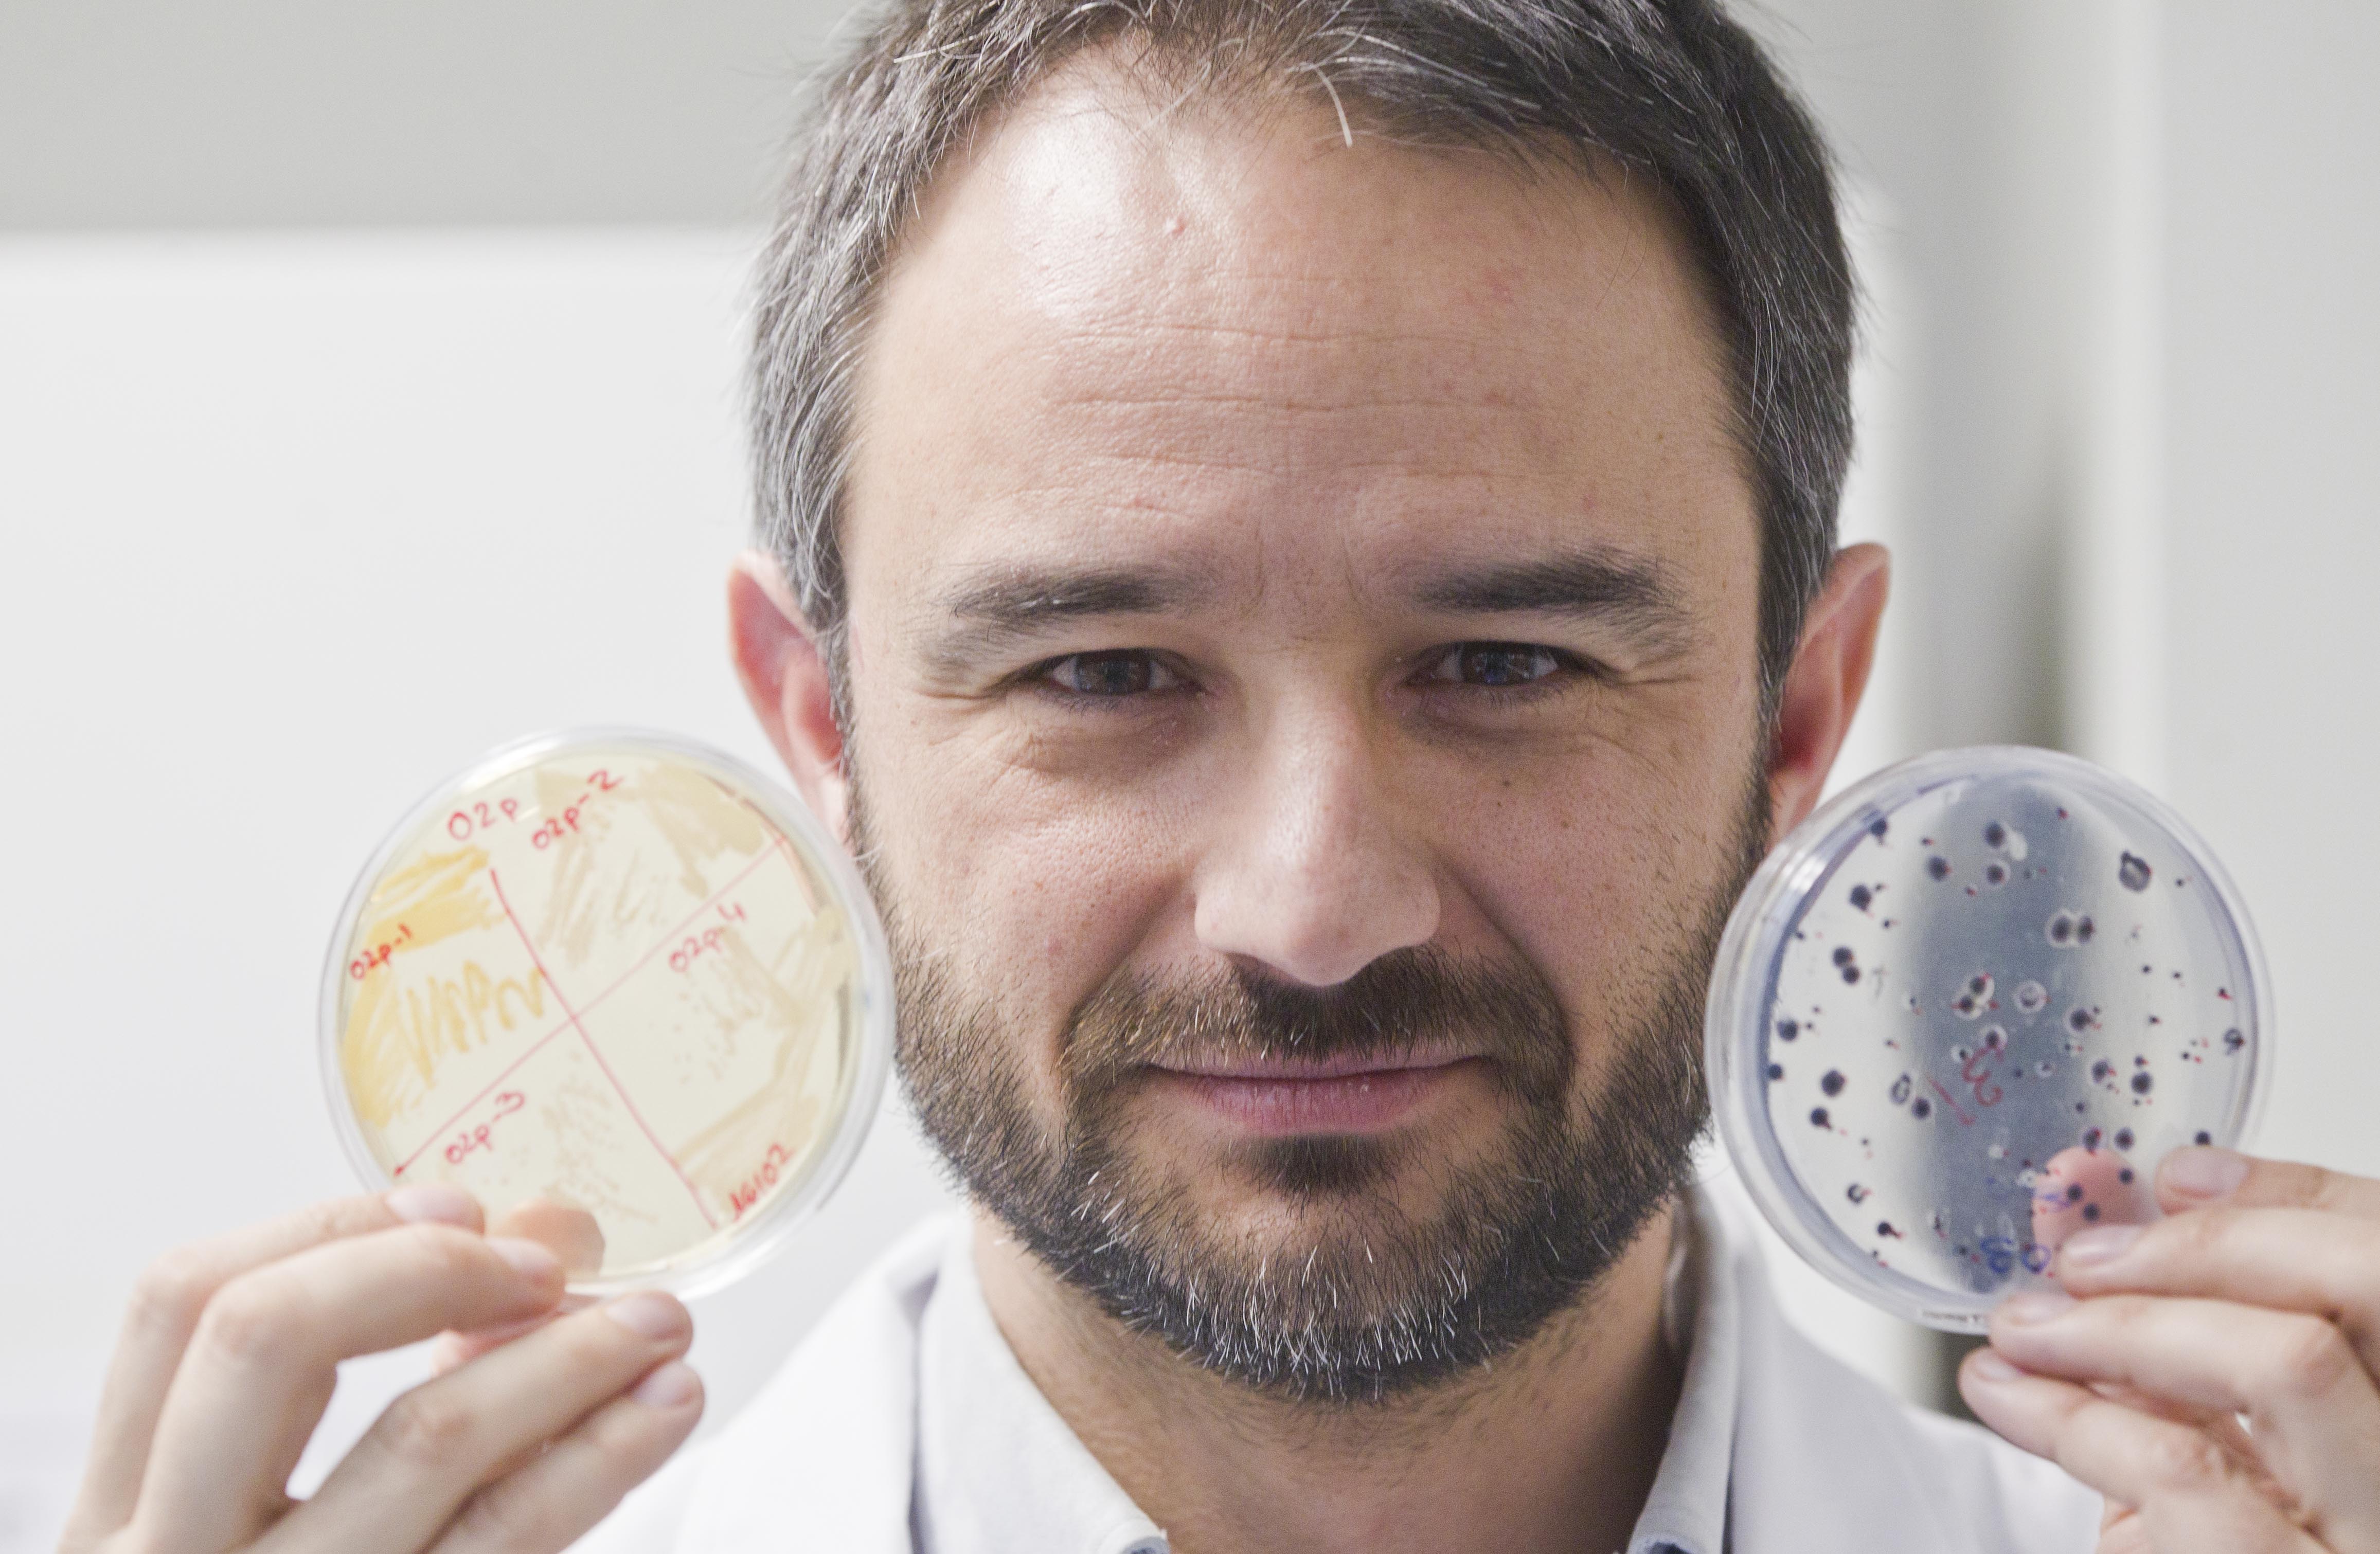
Alex Mira

Munnens betydelse för allmänhälsan
Ta del av två inspirerande föreläsningar om kopplingen mellan allmän- och munhälsa. 13 september har du chansen att lära dig mer om vad munnens betydelse har för allmänhälsan genom att lyssna till Alex Mira och Daniel Jönsson vid Centrum för odontologi och oral hälsa på Hälsohögskolan.
Grönsaker kan förbättra munhälsan
Alex Mira, forskare inom oral mikrobiologi och verksam vid Oral Microbiome Laboratory, FISABIo, Valencia, Spanien.
Det finns goda orala bakterier som kan påverka vår hälsa till det bättre. Många tänker på munbakterier som orsak till karies eller tandköttsinflammation – men det finns också de som är nyttiga.
- En god munhälsa förbättrar eller förebygger inte bara munsjukdomar utan kan även förebygga hjärt- och kärlsjukdomar, diabetes eller cancer. Den senaste forskningen menar jag bidrar till att sätta tandvård och munhälsa i centrum för människors allmänna hälsa, säger Alex Mira, forskare inom oral mikrobiologi och verksam vid Oral Microbiome Laboratory, FISABIo, Valencia, SpanienVissa av de här goda bakterierna kan omvandla nitrat, som finns i frukt och grönsaker som till exempel spenat och rödbetor, till nitrit och kväveoxid. Kväveoxid står för viktiga funktioner i kroppen och kan förebygga sjukdomar.
Tandlossning påverka mer än du tror
%20Daniel.jonsson.jpg)
Daniel Jönsson, specialist i parodontologi vid Folktandvården Skåne.
Vid exempelvis en halsinfektion kan kroppen bli allmänpåverkad och du kan känna dig trött och hängig eller få feber och frossa. Tandlossning är en ganska stor såryta, men som växer mycket långsamt, kan orsaka en allmänpåverkan som du inte märker av. Den är dock mätbar. En halsinfektion går snabbt över, men det gör sällan tandlossning. Den är snarare kronisk men behandlingsbar.
- Lyckligtvis ser man att allmänpåverkan minskar när man behandlar tandlossning. Därför är det också så viktigt att behandla, inte bara för att få behålla tänderna och ha en frisk mun utan för att också må bättre överlag, säger Daniel Jönsson, specialist i parodontologi vid Folktandvården Skåne.
Datum: 13 september 2023
Tid: kl.13:00-14:30 Alex Mira (Föreläsningen är på engelska)
kl. 14:30-15:00 Paus
kl. 15:00-16:30 Daniel Jönsson
Plats: Forum Humanum på Hälsohögskolan, Jönköping University eller digitalt via Zoom.
Länk till anmälan: https://esmaker.net/nx2/s.aspx?id=2f2667baa5d6